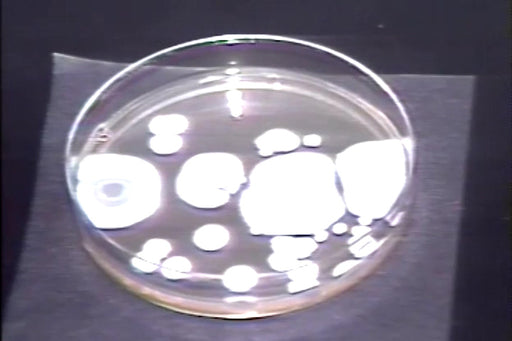

Hotel Safety

Hotel Safety Series - Lockout/Tagout
Control of hazardous energy sources is a requirement that organizations must implement for the safety of all employees. This program explains the...
View full details
Ladder Safety (Hospitality)
Thousands of individuals are injured from falling off a ladder each year. Most injuries are caused by slipping on grease, oil and solvents left on...
View full details
Hotel Safety Series - Fire Extinguisher Training
Fire extinguishers should be classified as first aid equipment. They are emergency treatment until professional help arrives. Do not put yourself...
View full details
Hotel Safety Series - Maintenance Person Safety
Maintenance persons are expected to do the impossible in the shortest time and at least expense. They are an extremely important part of any organ...
View full details
Hotel Safety Series - Sanitation and Health For Food Service Workers
Foodborne illness is quite prevalent in the home, restaurants, hotels, and retail establishments. Through someone's carelessness, micro-organisms ...
View full details